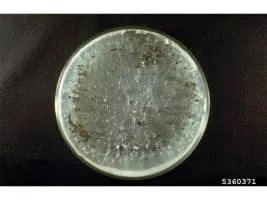

Athelia Rolfsii
| Use attributes for filter ! | |
| Scientific name | Athelia rolfsii |
|---|---|
| Kingdom | Fungi |
| Rank | Species |
| Higher classification | Athelia |
| Order | Atheliales |
| Division | Basidiomycota |
| Date of Reg. | |
| Date of Upd. | |
| ID | 2301834 |
About Athelia Rolfsii
Athelia rolfsii is a corticioid fungus in the family Atheliaceae. It is a facultative plant pathogen and is the causal agent of "southern blight" disease in crops.